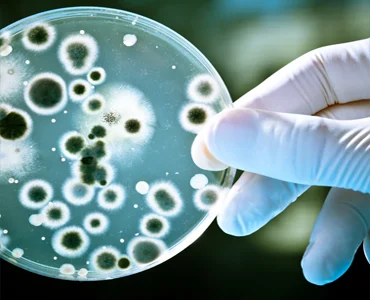

BIOX – Your Comprehensive Solution for Antimicrobial Needs
At Geocon Products, we are at the forefront of innovation, dedicated to developing cutting-edge Inorganic and Organic Antimicrobial, Antifungal, and Antivirus additives. Our mission is to bring hygiene and protection from harmful microbes into your daily life.
Our extensive product range caters to a wide spectrum of industrial applications, including coatings, inks, ceramics, textiles, leather, paper, and plastics. Geocon offers a holistic package of antimicrobial solutions, tailored to meet the unique requirements of our customers. Our product line, known as BIOX Antimicrobial additives, delivers exceptional and long-lasting performance.
Every aspect of our antimicrobial and antifungal additives has been rigorously tested on various substrates in accredited laboratories across India. We take pride in our commitment to quality and efficacy.
BIOX Anti Microbial Platforms
Our BIOX Anti Microbial Platforms encompass a range of advanced solutions:
- Inorganic : Featuring Silver Zirconium Phosphates, Silver Zeolites, and Zinc Oxide, Quaternary Silanes. these additives are designed to provide a robust defense against harmful microorganisms.
BIOX : Shielding and Safeguarding Against Microbes and Fungi
Incorporate the BIOX range of antimicrobial and antifungal additives into your manufacturing process to fortify your products against the threat of microbes, mildews, fungi, and viruses. These powerful additives, available in powdered, slurry, and emulsion forms, are seamlessly blended into your formulations, enhancing the protection and longevity of your finished products.
BIOX Anti Microbial and Anti-Fungi additives are the ideal choice for a wide range of applications, including coatings, inks, textiles, and polymers. They operate by remarkably inhibiting cell wall development by up to 99%, resulting in a substantial reduction in bacteria, mold, fungi, and viruses. With BIOX, your products are shielded against the forces of nature.
Choose BIOX for unmatched protection and peace of mind.
Frequently Asked Questions (FAQ) on Anti Microbials
What is a Microbe?
A microbe is an organism of microscopic size, which may exist in its single-celled form or as a colony of cells.
What are bacteria?
Bacteria are microscopic, single-celled organisms that exist in their millions, in every environment, both inside and outside other organisms.
What is Fungi?
Fungi are members of the group of eukaryotic organisms that includes microorganisms such as yeasts and molds.
What are the types of Bacteria or Microbes based on shape?
- There are various types of bacteria based on their shape:
- Spherical: Known as cocci, with a single bacterium referred to as a coccus.
- Rod-shaped: Known as bacilli (singular bacillus). Some rod-shaped bacteria are curved, known as vibrio.
- Spiral: Known as spirilla (singular spirillus). If their coil is very tight, they are known as spirochetes.
Are Anti Microbials and Anti-Fungi Additives the same?
No, antimicrobial additives are classified according to the microorganisms they primarily target. Anti-bacterials are used against bacteria, while antifungals are used against fungi.
What is the mechanism of Anti Microbials Additives?
An antimicrobial additive is an active ingredient that can be added to a formulation or finishing product during processing to inhibit the growth of microbes, often by disrupting the cell walls of bacteria.
What is the mechanism of Anti-Fungi Additives?
An antifungal additive is an active ingredient added to a formulation or finishing product during processing to inhibit the growth of fungi or fungus by breaking down their cell walls.
Are all Anti Microbials safe?
Antimicrobials are used in various products, including cleaning, healthcare, and industrial products, to prevent the growth of harmful microorganisms. Their safety depends on the specific antimicrobial and its intended use. Government agencies often regulate these products to ensure safety and efficacy.
Is Silver Anti Microbials safe?
Silver exhibits low toxicity in the human body, and there is minimal risk associated with clinical exposure through inhalation, ingestion, or dermal application.
Will adding Anti Microbial reduce the shelf life of the final product?
No, in fact, antimicrobial additives are often used in the formulation and finishing of industrial products to prolong shelf life. They achieve this by extending the lag phase and reducing the growth rate of microorganisms, thereby preserving the product's quality characteristics and safety.
BIOX Anti Microbial Products Portfolio
Shielding Consumer and Industrial products using Anti Microbial additives using specific chemistries of Biox hygiene additives. We are Manufacturing and Processing company with complete technical and formulation support providers to the end customers. In Industrial and Consumer applications microbes and Fungi protections need to be discussed closed with the confidentiality with the customers we provide fullest support to our customers.